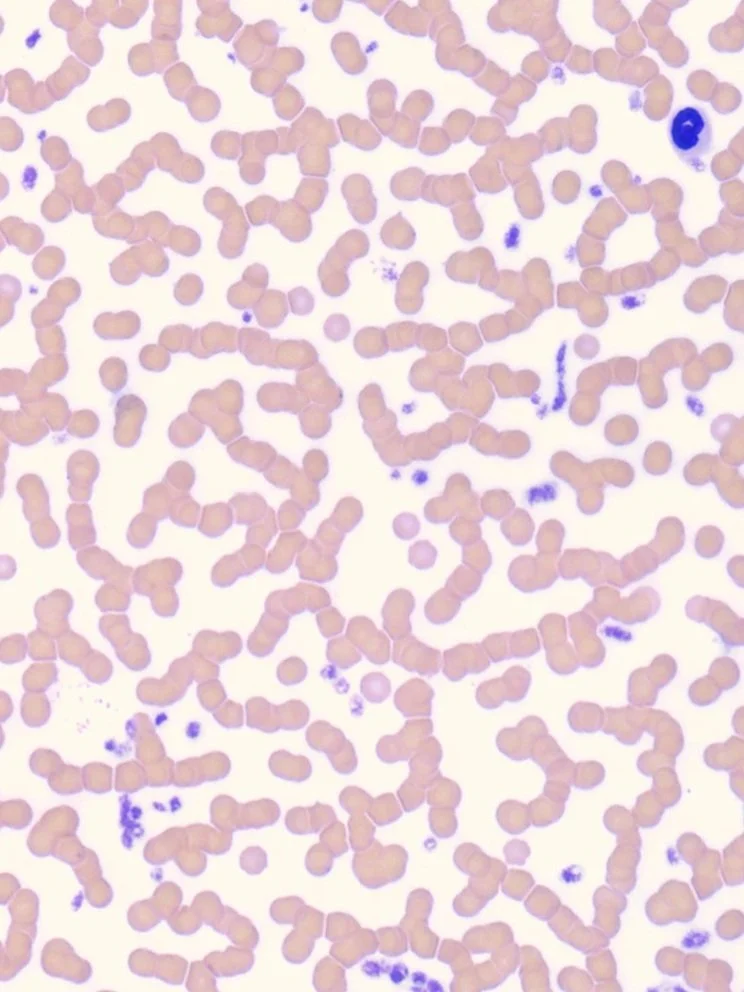

Clinically Significant RBC Morphological Abnormalities in Veterinary Practice
Erythrocyte morphological abnormalities represent critical diagnostic clues in hematological assessment. While modern automated analyzers provide increasingly sophisticated quantitative data, microscopic evaluation of blood films remains essential for identifying morphological changes that can dramatically narrow differential diagnoses and direct clinical intervention. This review focuses on the ten most clinically significant red blood cell (RBC) morphological abnormalities encountered in veterinary practice, their pathophysiological mechanisms, and diagnostic implications.
Clinical Significance
Primary Diagnostic Association: Immune-mediated hemolytic anemia (IMHA)
Other Causes:
Oxidative injury (zinc, onion, acetaminophen toxicity)
Snake envenomation
Bee stings
Hemolytic transfusion reactions
Species Considerations
Most readily identified in dogs; more challenging to recognize in cats due to smaller erythrocyte size and inherent minimal central pallor.
Diagnostic Value
According to Wardrop and Weiss (2020), the presence of >5 spherocytes per 100× oil immersion field demonstrates 92% sensitivity and 82% specificity for primary IMHA in dogs when other causes are excluded, highlighting the critical diagnostic importance of this morphological finding.
Clinical Significance
Primary Diagnostic Associations:
Disseminated intravascular coagulation (DIC)
Microangiopathic hemolytic anemia
Hemangiosarcoma (particularly splenic)
Severe heartworm disease
Vasculitis
Species Considerations
More commonly observed in dogs than cats; may be particularly prominent in hemangiosarcoma cases.
Diagnostic Value
Mechanick et al. (2019) demonstrated that moderate to marked schistocytosis (>10 schistocytes per 100× oil immersion field) in dogs had a positive predictive value of 78% for underlying vascular neoplasia or DIC, emphasizing the need for thorough investigation of this finding.
Clinical Significance
Primary Diagnostic Associations:
Toxin exposure (onions, garlic, zinc, propylene glycol, acetaminophen, vitamin K analogs)
Hypophosphatemia (especially in diabetic cats)
Methylamine-containing compounds
Certain drugs (phenazopyridine, methylene blue)
Species Considerations
Feline erythrocytes are particularly susceptible to Heinz body formation due to a higher number of sulfhydryl groups in hemoglobin and reduced ability to reduce methemoglobin. Physiologic Heinz bodies (1-2 per cell) may be observed in up to 10% of erythrocytes in healthy cats.
Diagnostic Value
Christopher et al. (2018) reported that Heinz body formation affecting >40% of erythrocytes in cats had 95% specificity for underlying oxidative damage, most commonly associated with toxin exposure, diabetes mellitus, or hyperthyroidism.
Acanthocytes
Morphological Characteristics
Acanthocytes (spur cells) appear as erythrocytes with irregularly spaced, blunt-tipped projections of variable size and distribution around the cell membrane.
Pathophysiological Mechanism
Abnormal cholesterol-to-phospholipid ratios in the erythrocyte membrane typically result from altered plasma lipid composition. This creates membrane instability, leading to irregular protrusions.
Clinical Significance
Primary Diagnostic Associations:
Hepatobiliary disease (particularly lipidosis in cats, chronic hepatitis in dogs)
Hemangiosarcoma (particularly splenic)
Glomerular disorders with protein loss
Liver lobe torsion
Species Considerations
More frequently observed in cats with hepatic lipidosis; in dogs, often associated with hemangiosarcoma or chronic hepatopathy.
Diagnostic Value
Zaldívar-López et al. (2020) demonstrated that moderate to marked acanthocytosis (>5% of RBCs) had an 87% positive predictive value for underlying splenic hemangiosarcoma or significant hepatic disease in dogs, highlighting the importance of further diagnostic investigation when this morphological finding is identified.
Echinocytes
Morphological Characteristics
Echinocytes (crenated cells) appear as erythrocytes with numerous small, evenly spaced, sharp projections distributed regularly around the cell periphery, creating a "sea urchin" appearance.
Pathophysiological Mechanism
Typically arise from altered cell membrane permeability due to pH changes, electrolyte imbalances, or in vitro artifact during blood storage. Physiologic echinocytes maintain normal cell volume unlike pathologic forms.
Clinical Significance
Primary Diagnostic Associations:
Uremia (decreased pH)
Electrolyte abnormalities (particularly hypernatremia)
Snake envenomation
Phosphofructokinase deficiency
Critical Consideration: Artifact due to slow drying, EDTA storage, or edge effect
Species Considerations
Canine erythrocytes are more prone to echinocyte formation as an artifact than feline erythrocytes; careful differentiation from true pathologic forms is required.
Diagnostic Value
In fresh blood smears, this finding is critical to identifying rattlesnake envenomation in both dogs and cats. Clinical signs such as focal to diffuse swelling, prolongation of PT/PTT, and/or history of potential exposure are important for consideration for definitive diagnosis.
Barger et al. (2019) noted that true pathologic echinocytosis affecting >20% of erythrocytes (excluding slide edge areas) in freshly prepared blood films demonstrated 72% specificity for underlying electrolyte disturbances or uremia in dogs, emphasizing the importance of distinguishing true pathologic forms from artifactual crenation.
Clinical Significance
Primary Diagnostic Associations:
Oxidant toxin exposure (acetaminophen, onions, zinc, mothballs)
Red maple leaf toxicity (horses)
Certain drug reactions
True hypochromasia: Iron deficiency, lead poisoning
Species Considerations
Horses particularly sensitive to red maple leaf toxicity with characteristic eccentrocyte formation; dogs sensitive to onion/garlic compounds; iron deficiency hypochromasia rare in cats.
Diagnostic Value
According to Olver and Smith (2021), the presence of >3% eccentrocytes on a blood film has 95% specificity for underlying oxidative damage to erythrocytes, warranting immediate investigation for potential toxin exposure.
Clinical Significance
Primary Diagnostic Associations:
Lead poisoning (classic association)
Other heavy metal toxicities (zinc, mercury)
Dyserythropoietic disorders
Severe regenerative responses (less common)
Species Considerations
Most commonly observed in dogs and cats with lead toxicity; may be seen alongside nucleated RBCs in regenerative responses but typically exhibits a different pattern and distribution from polychromasia.
Diagnostic Value
Thrall et al. (2023) reported that moderate to marked basophilic stippling in non-regenerative anemias had 88% positive predictive value for underlying lead or heavy metal toxicity when other causes were excluded, highlighting the importance of this distinctive morphological finding.
Agglutination
Morphological Characteristics
Irregular clustering of erythrocytes that persists in diluted blood and cannot be dispersed by gentle agitation, distinguishing it from rouleaux formation.
Pathophysiological Mechanism
Results from antibody-mediated cross-linking of erythrocytes, with IgM antibodies particularly efficient at causing agglutination due to their pentameric structure with multiple binding sites.
Clinical Significance
Primary Diagnostic Associations:
Immune-mediated hemolytic anemia (primary or secondary)
Transfusion reactions
Cold agglutinin disease
Some infectious diseases (e.g., hemoplasmosis)
Species Considerations
More commonly observed in dogs than cats; degree of agglutination may fluctuate with body temperature in cold agglutinin disease.
Diagnostic Value
Macrotubule slide agglutination testing provides rapid confirmation of suspected agglutination. According to Garden et al. (2019), persistent macroscopic agglutination in properly collected and handled blood samples had 96% specificity for immune-mediated hemolytic anemia in dogs, making this a critically important finding in diagnostic hematology.
Rouleaux Formation
Morphological Characteristics
Linear stacking of erythrocytes resembling "stacks of coins" that disperses with saline dilution, distinguishing it from true agglutination.
Pathophysiological Mechanism
Results from altered plasma protein composition (typically hyperglobulinemia) that reduces the normal negative surface charge on erythrocytes, allowing closer approximation and temporary adhesion.
Clinical Significance
Primary Diagnostic Associations:
Inflammatory conditions with hyperglobulinemia
Monoclonal gammopathies (multiple myeloma, lymphoma)
Hyperproteinemia of various causes
Pregnancy (mild)
Species Considerations
Normal finding in horses and cats; pathologic when excessive in dogs. Must be distinguished from true agglutination.
Diagnostic Value
Increased rouleaux formation warrants assessment of plasma proteins. Nelson et al. (2018) demonstrated that marked rouleaux formation in canine blood films had 76% positive predictive value for concurrent hyperglobulinemia >4.5 g/dL, indicating the need for protein electrophoresis.
Blood Parasites
Morphological Characteristics
Various morphologies depending on the parasite; may appear as intracellular inclusion bodies (Babesia, Cytauxzoon), extracellular organisms (microfilariae), or attached ectoparasites (Haemobartonella/Mycoplasma).
Pathophysiological Mechanism
Direct parasitization of erythrocytes leading to hemolysis through membrane damage, altered metabolism, or immune-mediated clearance of infected cells.
Clinical Significance
Primary Diagnostic Associations:
Babesia spp. (small and large forms)
Mycoplasma haemofelis (formerly Haemobartonella)
Cytauxzoon felis
Hepatozoon spp.
Dirofilaria immitis (microfilariae)
Species Considerations
Species-specific parasites with distinct geographic distributions; may require specialized staining techniques for optimal visualization.
Diagnostic Value
Early detection of blood parasites can be life-saving. According to Birkenheuer et al. (2022), careful blood film examination by experienced personnel detected approximately 85% of parasitemic cases in symptomatic animals, though PCR testing is recommended in suspected cases with negative microscopic findings due to higher sensitivity.
Conclusion
Systematic evaluation of erythrocyte morphology remains an essential diagnostic skill in veterinary hematology despite advances in automated analyzers. The ten morphological abnormalities reviewed here provide critical diagnostic clues that can rapidly narrow differential diagnoses, guide further testing, and inform therapeutic decision-making. Familiarity with these key morphological alterations, their pathophysiological mechanisms, and their clinical associations enhances the diagnostic value of routine blood film examination and ultimately improves patient care.
References
Wardrop, K.J., & Weiss, D.J. (2020). Schalm's Veterinary Hematology (7th ed.). Wiley-Blackwell.
Thrall, M.A., Weiser, G., Allison, R.W., & Campbell, T.W. (2023). Veterinary Hematology and Clinical Chemistry (3rd ed.). Wiley-Blackwell.
Harvey, J.W. (2021). Atlas of Veterinary Hematology